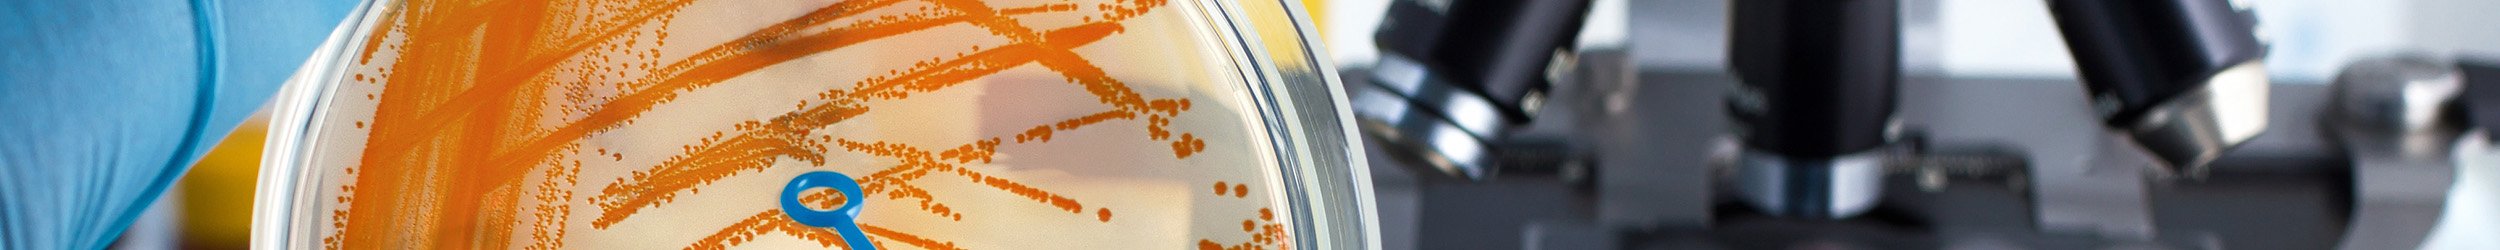
Gloved hand holding petri dish with orange bacteria and loop, microscope in background.

Microbiology/Cell & Molecular Biology
Majors
Pre-Medical Professional, BS
Microbiology is the study of bacteria, viruses, fungi and protozoa and their many relationships to humans, animals and plants. Courses in the Department of Microbiology and Molecular Genetics are designed to provide comprehensive training in microbiology and molecular biology and the skills required to work with microorganisms that span the spectrum of microbial life.
Program Highlights
- Learn in newly renovated labs with state-of-the-art equipment.
- Gain hands-on experience through undergraduate research opportunities.
- Microbiology students have a wide range of interests from medical school to law school, to grad school, with dual majors ranging from biochemistry to foreign languages.
Potential Careers
- Physician
- Forensic Science
- Genetic Counseling
- Drug Manufacturing
- Food Science
- Medical Laboratory Science
- Assistant Professor
- Research
- Veterinarian
- Dentist
Courses to Look For
- Brewing Microbiology
- Immunology
- Cell and Molecular Biology Infectious Disease
- Environmental Microbiology
- Pathogenic Microbiology
- Virology
- Microbial Physiology and Ecology
- Microbiomes in Home, Health, and Environment
Research and Opportunities
- Research opportunities starting freshman year
- Student Chapter of the American Society for Microbiology
- OK-Louis Stokes Alliance for Minority Participation (LSAMP)
Student Internships
- Working with our Career Service advisors, you have numerous opportunities for internships in a non-profit organization, a government office, or a private/public for profit business. The placement may be paid or unpaid, and/or count for academic credit.
- Medical Laboratory Scientist, Saint Francis Hospital - Tulsa, OK
- Undergraduate Researcher
Get Involved
- Stay active on campus while making lifelong friends.
- Get involved with groups, such as:
- Microbiology Club
- Global Medical Brigades
- CAS Student Council
- CAS Ambassadors
- Microbiology Ambassadors